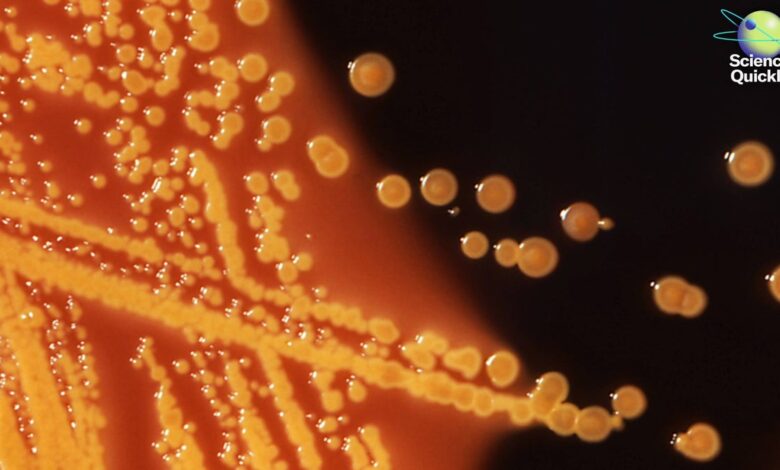

WHO hlásí globální nárůst antibiotické rezistence a úmrtí na superbakterie
Globální nárůst superbugů, Chikungunya zasáhla Long Island a údaje o úniku satelitů
Nová zpráva WHO varuje před rostoucí antimikrobiální rezistencí a výzkumníci odhalují úniky satelitních dat a hmyzí překvapení.
Smith Collection/Gado/Contributor/Getty Images
Rachel Feltmanová: Krásné pondělí, posluchači! Pro Scientific American‚s Věda rychle, Jsem Rachel Feltmanová. Začněme týden rychlým shrnutím některých nejnovějších vědeckých zpráv.
Minulé pondělí Světová zdravotnická organizace varovala, že bakteriální infekce odolné vůči lékům jsou na celém světě na vzestupu. Podle WHO superbakterie, které jsou antimikrobiálně odolné, neboli AMR, přispěly k téměř pěti milionům úmrtí v roce 2019 a nesly přímou odpovědnost za více než jeden milion. Do roku 2023 jedna ze šesti laboratorně potvrzených bakteriálních infekcí vykazovala rezistenci vůči antibiotikům více než 40 procent běžně používaných léků v těchto případech ztratily účinnost během posledních pěti let. Země s nízkými a středními příjmy měly větší pravděpodobnost, že budou mít rezistenci na antibiotika New York Times. A ve skutečnosti může být situace ještě horší, než se zdá: WHO poznamenala, že pouze 48 procent zemí skutečně sdílelo údaje o antimikrobiální rezistenci a zhruba polovina z nich neměla sledovací systémy. Zlepšení dohledu v nadcházejících letech bude klíčové v boji proti superbakteriím, uvedla agentura.
Přibližujeme některé lokalizovanější zprávy o veřejném zdraví a některé mnohem větší chyby. Představitelé New Yorku minulé úterý potvrdili, že obyvatel Long Islandu měl pozitivní test na virus chikungunya. Infikovaný jedinec, který žije v okrese Nassau, údajně odcestoval z okresu, ale ne mezinárodně, než se nakazil nemocí přenášenou komáry, což je první hlášený přenos v USA od roku 2019.
O podpoře vědecké žurnalistiky
Pokud se vám tento článek líbí, zvažte podporu naší oceňované žurnalistiky předplatné. Zakoupením předplatného pomáháte zajistit budoucnost působivých příběhů o objevech a nápadech, které formují náš dnešní svět.
Virus Chikungunya přenášejí dva typy komárů, z nichž jeden se vyskytuje na Long Islandu. Virus může způsobit silnou bolest kloubů, která v některých případech přetrvává měsíce nebo dokonce roky. Mezi další příznaky patří horečka, bolest svalů, nevolnost, bolest hlavy, otoky kloubů, únava a vyrážka. Zatímco většina lidí se plně uzdraví během týdne nebo tak, někteří mohou zaznamenat vážné oční, srdeční a neurologické komplikace. Tyto závažné případy jsou nejčastější u kojenců, starších dospělých a jedinců se základním zdravotním stavem. Zatímco se virus obecně přenáší kousnutím komárem, je možné, že novorozenec chytí chikungunya od svého rodiče během porodu.
Naposledy jsme byli svědky místního přenosu chikungunya v USA a na jejich územích v roce 2019. Přenos v rámci států a území začal o pět let dříve, když se případy objevily na Floridě, v Texasu, Portoriku a na Amerických Panenských ostrovech po nárůstu počtu lidí vracejících se z mezinárodních cest nesoucích virus, podle Centra pro kontrolu a prevenci nemocí. Jakmile někdo přinese virus domů, je možné, že ho místní komáři kousnou, získají infekci a přenesou ji na ostatní.
Nejlepší je, že zdravotničtí úředníci nenašli známky pokračujícího přenosu – a když se podzimní počasí konečně ustálilo, je nepravděpodobné, že místní komáři budou v nadcházejících týdnech představovat velkou hrozbu. Lidé cestující do zahraničí by však měli být stále na pozoru: virus se aktivně šíří v několika zemích, včetně Číny, která podle WHO zažívá své největší propuknutí v historii.
Zde je několik zpráv o zdraví, které můžete použít z Scientific Americanlistopadové tištěné vydání: Které doplňky skutečně pomáhají snižovat chronický zánět? Po hledání konzistentních výsledků v několika velkých, dobře navržených studiích SciAm přistál na třech: omega-3 mastných kyselinách, sloučenině zvané kurkumin, která se nachází v kurkumě a vitaminu D, což může být prospěšné pro některé stavy. Další podrobnosti o důkazech za těmito protizánětlivými činidly naleznete na ScientificAmerican.com nebo se podívejte na naše nejnovější tištěné vydání ve vašem oblíbeném novinovém stánku.
Nyní přejděme k některým vesmírným novinkám.
Vědci analyzují data ze satelitů Swarm Evropské vesmírné agentury zjistili, že zranitelná oblast v ochranném magnetickém štítu Země nad jižním Atlantikem se za posledních 11 let rozrostla o oblast zhruba poloviční velikosti kontinentální Evropy. Podle nedávné studie v Fyzika Země a planetárních vnitřkůtyto změny pocházejí z neobvyklé aktivity, kde se vnější jádro roztaveného železa Země setkává s vrstvou skalního pláště a vytváří oblasti, kde je směr magnetického pole obrácen. Autoři studie říkají, že tato slabá zóna představuje riziko pro satelity a kosmické lodě, které tudy procházejí, protože vystavuje objekty zvýšené radiaci, která může poškodit jejich elektroniku.
Když už mluvíme o satelitech, ukazuje se, že mnohé z těch, které jsou v současné době na oběžné dráze, by mohly ohrožovat citlivé informace. Minulý týden představil tým výzkumníků z Kalifornské univerzity v San Diegu a Marylandské univerzity novou studii o satelitní komunikaci na konferenci Association for Computing Machinery na Tchaj-wanu.
Vědci namířili na oblohu běžně dostupný satelitní přijímač, aby viděli, jaká data mohou sbírat. Pomocí jednoduchého nastavení na jediné střeše v San Diegu byl tým schopen pozorovat satelitní komunikaci z téměř 15 procent geostacionárních zařízení, která jsou v současné době v provozu. Aaron Schulman, profesor UCSD, který spoluvedl výzkum, řekl Kabelové že jeho tým očekával, že většina informací, které obdržel v těchto signálech, bude zašifrována. Místo toho tým zachytil telefonní hovory a textové zprávy od tisíců zákazníků T-Mobile během pouhých několika hodin, viděl, co lidé kontrolují na Wi-Fi v letadle, a dokonce zachytil komunikaci týkající se vojenských vrtulníků – to vše proto, že se nikdo neobtěžoval šifrovat data.
Když vědci koncem roku 2024 začali upozorňovat společnosti a agentury na tento problém, někteří, jako T-Mobile, rychle přidali šifrování. Ale vědci říkají, že ostatní stále nezajistili své systémy.
Zakončíme skvělým zvířecím příběhem. Ve studiu zveřejněno minulý čtvrtek v Věda páchnouci se ukazují být, ne-li příjemnější, než přinejmenším zajímavější, než se dříve předpokládalo. Je známo, že samice páchníků z čeledi Dinidoridae mají na zadních nohách zvětšenou strukturu, kterou vědci považovali za bubínkový orgán. Jedná se o jednoduchý sluchový orgán, který se vyskytuje u mnoha druhů hmyzu.
Ale když se výzkumníci podívali na jeden druh z této čeledi, našli něco neočekávaného: tato podivná struktura nohou je ve skutečnosti houbová školka. Povrch struktury je plný drobných pórů, ze kterých vyrůstají vlákna symbiotické houby. Když se páchníci rozmnoží, přenesou si část plísní záměrně na vajíčka. Jak houba roste, zdá se, že nabízí fyzickou ochranu proti parazitickým vosám.
To je vše pro shrnutí vědeckých zpráv tohoto týdne. Ve středu se vrátíme, abychom se naučili tajný recept na vytvoření přesvědčivé omluvy.
Věda rychle produkuji já, Rachel Feltman, spolu s Fondou Mwangi a Jeffem DelVisciem. Tuto epizodu upravil Alex Sugiura. Shayna Posses a Aaron Shattuck – podívejte se na naši show. Naši tematickou hudbu složil Dominic Smith. Přihlásit se k odběru Scientific American pro více aktuálních a hloubkových vědeckých zpráv.
Pro Scientific American, tohle je Rachel Feltmanová. Krásný týden!




